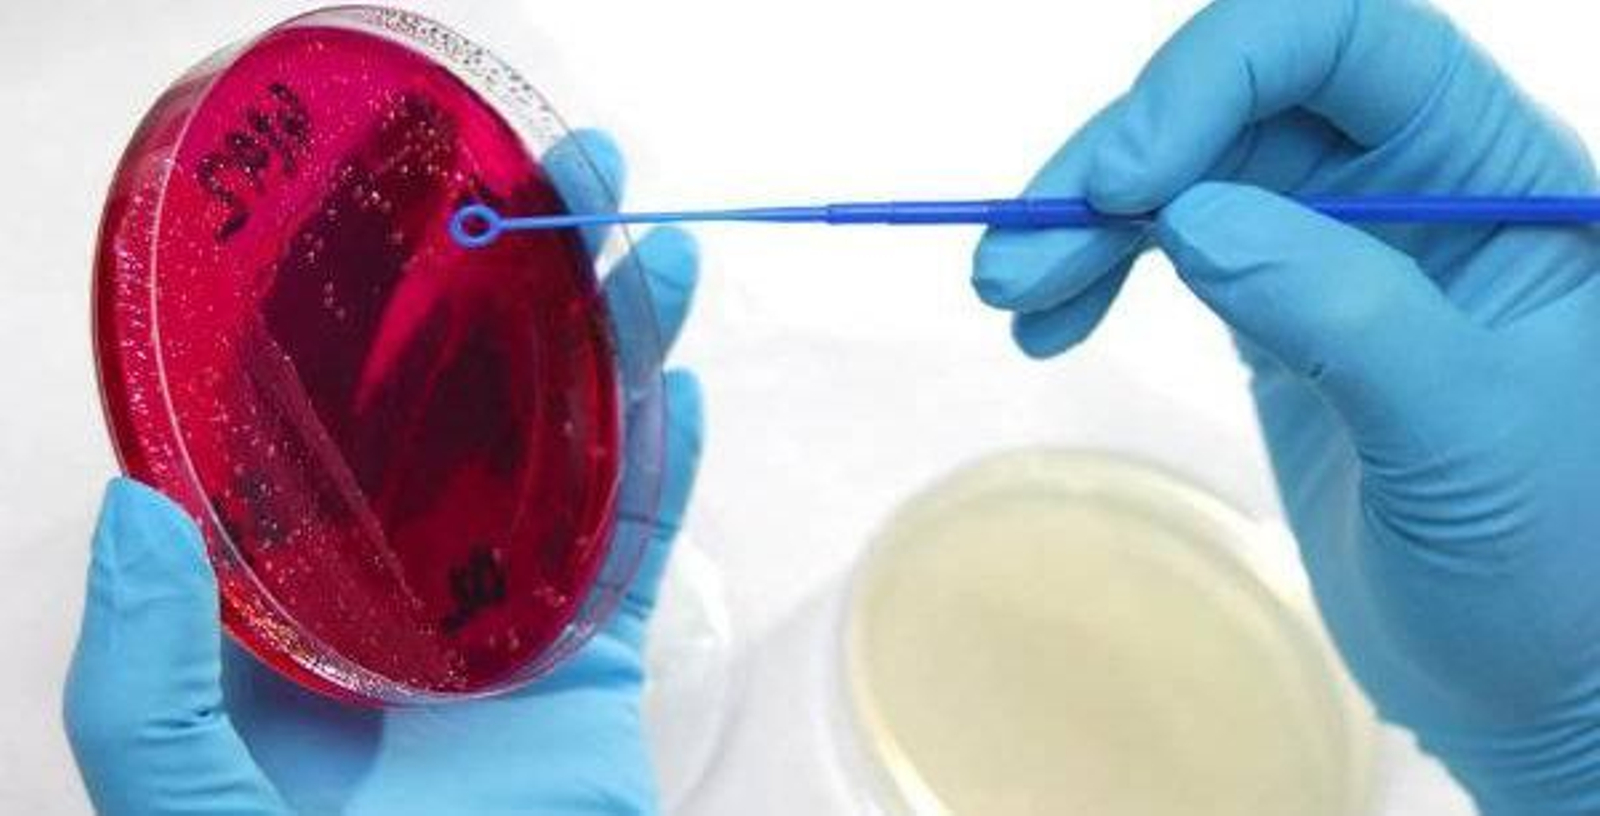
Laboratorios_IIIModif.JPG_729600497

13 ago 2024
Arde Grecia: más de 50.000 evacuados en un incendio que cerca Atenas
Grecia también sufrió un verano devastador, con decenas de incendios que quemaron un récord de 160.000 hectáreas, equivalente al 1,21% de su territorio, y donde 28 personas perdieron la vida a causa de las llamas.